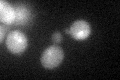
YKL090W
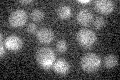
YKL090W

View description
Protein of unknown function; has two CUE domains that bind ubiquitin, which may facilitate intramolecular monoubiquitination
Localization:
Intensity:
Fold change:
Significance:
-
C’ GFP library in SD

below threshold18.02 -
N' NOP1pr-GFP in SD

cytosol80.6412 -
N' TEF2pr-mCherry in SD

cytosol0 -
N' NATIVEpr-GFP in SD

below threshold18.6784 -
N' TEF2pr-VC and Cyto-VN in SD

cytosol54.7785 -
C’ GFP library in SD+DTT
cytosol18.711.03No -
C’ GFP library in SD+H2O2

cytosol17.360.96No -
C’ GFP library in Starvation Media
cytosol14.890.82No -
C’ GFP library on the background of Pup2-DaMP

below threshold -
C’ GFP library on the background of CCT mutant

below threshold17.30440.959881No
